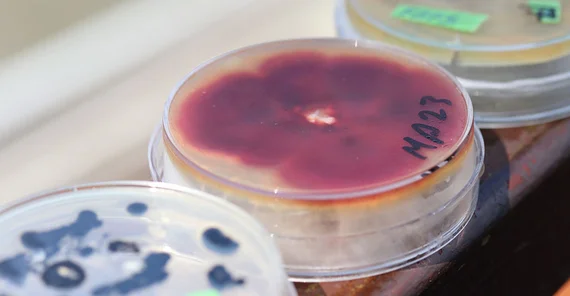
Wasserpilz-Kulturen

Prof. Dr. Hans-Peter Grossart forscht hier seit über 20 Jahren und hat dabei vor allem die unscheinbaren Mikroorganismen im Blick, die zwar eine geringe Größe, aber großen Einfluss auf die Stoff- und Energiekreisläufe der Gewässerökosysteme haben. Er leitet die Forschungsgruppe Aquatische mikrobielle Ökologie und ist zugleich Professor an der Universität Potsdam. Wie Bakterien, winzige Algen, Amöben oder Wimperntierchen zusammenspielen, sich gegenseitig beeinflussen und das Nahrungsnetz in Gewässern wie dem Stechlinsee prägen, untersucht er hauptsächlich mit molekularbiologischen Methoden und mathematischen Modellen. Seit einigen Jahren drängt sich eine weitere Gruppe von Lebewesen in sein Blickfeld: die Pilze.
Der Klimaschrank in seinem Labor ist gut gefüllt. Zahlreiche Petrischalen stapeln sich hier und beherbergen jede Menge Pilzarten, die ursprünglich aus dem Stechlinsee stammen. „Mit den Pilzen aus dem Wald hat das nichts zu tun, die haben wenigstens einen vernünftigen Fruchtständer“, sagt Grossart lachend. Auf dem Nährmedium in der Petrischale wachsen stattdessen rote, schwarze oder gelbliche Zellhaufen, deren Struktur sich erst unter dem Mikroskop offenbart. Dann erkennt man die zarten Pilzhyphen: fadenförmige Zellen, die verzweigte Netze bilden. In kugelrunden oder ovalen Ausstülpungen wächst der Nachwuchs heran: winzige Zoosporen, die beim Platzen der Kapsel ins Wasser gelangen und sich mit ihren Geißeln fortbewegen, um neuen Lebensraum zu besiedeln.
„Allein im Stechlinsee gibt es Tausende dieser Pilzarten, wir entdecken jedes Jahr viele neue“, sagt Grossart. Im Nahrungsnetz übernehmen sie eine wichtige Aufgabe: Sie bauen totes organisches Material ab, bilden daraus Biomasse und setzen Nährstoffe frei. Mit einem Druck von bis zu 200 Bar kann eine Pilzhyphe eine Pflanzenzelle durchbrechen und in das Gewebe eindringen. Die pilzlichen Enzyme können dabei auch hochkomplexe organische Verbindungen abbauen, die für andere Organismen unverdaulich sind. Abgefallenes Laub, tote Algen und Tiere oder Pollen werden rasch besiedelt und verwertet. Das Pilzgewebe wird wiederum von kleinen Krebstierchen oder Insektenlarven „abgegrast“. Der Nährstoffkreislauf schließt sich.
Wie bedeutend die Pilzgemeinschaft für Gewässer ist, zeigt sich auch, wenn unbeabsichtigt Fungizide aus der Landwirtschaft in die Gewässer hineingelangen. Die gegen Pilzerkrankungen eingesetzten Mittel hemmen auch das Wachstum der aquatischen Pilze. Die Folgen sind im Ökosystem spürbar: „Man sieht weniger Pilzbiomasse, und das beeinflusst das Nahrungsnetz. Der Blattabbau wird etwa gehemmt, es wird weniger mikrobielle Biomasse gebildet, die wiederum Nahrungsgrundlage für Krebstierchen ist“, erklärt Grossart.
Aquatische Pilze wachsen jedoch nicht nur auf totem Material. Als Parasiten besiedeln sie auch lebende Organismen wie zum Beispiel Algen. „Das ist schon seit rund 100 Jahren bekannt“, weiß Mikrobiologe Grossart. „Aber trotzdem wissen wir noch sehr wenig über die Einzelheiten dieser parasitischen Beziehung.“
Dass gerade dieses Phänomen für den Stoffkreislauf und das Nahrungsnetz von Gewässern sehr wichtig ist, hat er kürzlich mit seinem Forschungsteam aufgedeckt: Mit Laborexperimenten und mathematischer Modellierung konnten die Forschenden zeigen, dass die beweglichen Fortpflanzungsstadien der Pilze – die Zoosporen – sehr nährstoffreich sind und gut von kleinen Zooplanktonorganismen wie Hüpferlingen und Wasserflöhen genutzt werden. Normalerweise fressen diese Krebstierchen vor allem einzellige Algen. Wenn das Wasser sehr nährstoffreich ist, werden die Einzeller oft von fädigen oder koloniebildenden Algen verdrängt – zum Nachteil der Krebstierchen. Werden die Algen aber von Pilzen parasitiert und bilden viele Zoosporen, haben Wasserflöhe trotzdem ausreichend Nahrung – statt Algen nehmen sie eine Pilzmahlzeit zu sich. Pilzforscher nennen dieses Phänomen „Mycoloop“, da es im Nahrungsnetz eine neue Querverbindung zwischen fädigen Algen und Zooplankton schafft. „Gerade diese Querverbindungen stabilisieren die Nahrungsnetze und machen sie unempfindlicher gegenüber Störungen“, betont Grossart.
Der Gewässerökologe ist überzeugt, dass aquatische Pilze noch weitere Überraschungen parat haben. In seinem Labor entdeckt er mithilfe der Genomsequenzierung nicht nur jede Menge neuer Arten, die er analysiert und beschreibt. Grossart untersucht auch, welche Gene bei ihnen aktiv sind, welche Enzyme sie bilden, welche Verbindungen sie damit abbauen, auf welchen Wirten sie parasitieren und wie sie deren Stoffwechsel beeinflussen. In einem aktuellen Forschungsprojekt will er herausfinden, was die Artenzusammensetzung der Pilze über die Wasserqualität verraten kann. „Es gibt viele Pilze, die sehr gut an bestimmte Verschmutzungen angepasst sind.“ Sie wachsen etwa bei hohen Schwermetallkonzentrationen oder können komplexe Farbstoffe aus der Textilindustrie abbauen. „All das ist noch nicht systematisch untersucht worden. Aber das wird kommen.“
Dieser Text erschien im Universitätsmagazin Portal - Zwei 2022 „Artensterben“ (PDF).